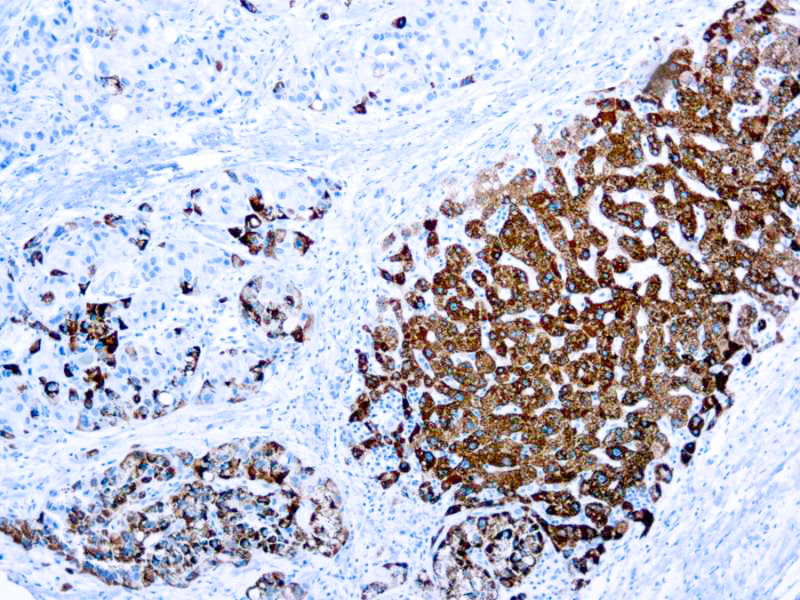

Hepatoblastoma is the most common primary tumor of the liver in children. The use of specific hepatocyte markers and also of α fetoprotein or carcinoembryonic antigen are useful for the identification of normal and malignant fetal hepatocytes. This antibody recognizes an uncharacterized antigen present in both adults and fetal normal hepatocytes to produce a distinct granular cytoplasmic staining. This antibody stains majority of hepatocellular carcinomas.
Hepatocyte Specific Antigen (OCH1E5)
SKU: Mob426-
Categories: Primary Antibodies, IVD - For U.S. Market, IVD - Outside U.S. Market
Tags: HL72K-Core Kit, Concentrated, H, Highlighter Product
Description
Additional information
| Clone | OCH1E5 |
|---|---|
| Isotype | IgG1 |
| Immunogen | Human liver fixed in formalin. |
| Species | Mouse |
| Cellular Localization | Cytoplasmic |
| Positive Control Tissue | Liver |
| Pretreatment | Citrate Buffer pH 6.0 |
| Incubation & Temperature | 30 min @ RT |
| Intended Use | IVD |
| Detection System | PolyVue Plus – Two Step Detection System or Montage PolyVue Plus Auto Detection System for Montage 360 System |
| Description/Type | Mouse Monoclonal Antibody |
| Format | This product is supplied as a purified immunoglobulin and contains sodium azide as a preservative. |
DATASHEETS & SDS
DATASHEETS & SDS
| Download Datasheet |
| Download SDS Sheet – OSHA |
REFERENCES
REFERENCES
- Amarapurkar et al. Indian J Pathol Microbiol 49 (3): 341, 2006.
- Chu et al. Am J Surg Pathol 26 (8): 978, 2002.
- Fasano et al. Mod Pathol 11: 934, 1998.
- Lamps and Folpe Adv Anat Pathol 10 (1): 39, 2003.
- Siddiqui et al. Cancer Cytopathol 96 (1): 49, 2002.
Reviews (0)
Only logged in customers who have purchased this product may leave a review.

Reviews
There are no reviews yet.